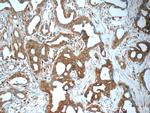
ARFGAP3 Antibody in Immunohistochemistry (Paraffin) (IHC (P))

Search
Proteintech
ARFGAP3 Polyclonal Antibody
{{$productOrderCtrl.translations['antibody.pdp.commerceCard.promotion.promotions']}}
{{$productOrderCtrl.translations['antibody.pdp.commerceCard.promotion.viewpromo']}}
{{$productOrderCtrl.translations['antibody.pdp.commerceCard.promotion.promocode']}}: {{promo.promoCode}} {{promo.promoTitle}} {{promo.promoDescription}}. {{$productOrderCtrl.translations['antibody.pdp.commerceCard.promotion.learnmore']}}
产品信息
15293-1-AP
种属反应
宿主/亚型
分类
类型
抗原
偶联物
形式
浓度
规格
纯化类型
保存液
内含物
保存条件
运输条件
产品详细信息
Immunogen sequence: MGDPSKQDI LTIFKRLRSV PTNKVCFDCG AKNPSWASIT YGVFLCIDCS GSHRSLGVHL SFIRSTELDS NWSWFQLRCM QVGGNASASS FFHQHGCSTN DTNAKYNSRA AQLYREKIKS LASQATRKHG TDLWLDSCVV PPLSPPPKEE DFFASHVSPE VSDTAWASAI AEPSSLTSRP VETTLENNEG GQEQGPSVEG LNVPTKATLE VSSIIKKKPN QAKKGLGAKK GSLGAQKLAN TCFNEIEKQA QAADKMKEQE DLAKVVSKEE SIVSSLRLAY KDLEIQMKKD EKMNISGKKN VDSDRLGMGF GNCRSVISHS VTSDMQTIEQ ESPIMAKPRK KYNDDSD (1-346 aa encoded by BC005122)
靶标信息
The protein encoded by this gene is a GTPase-activating protein (GAP) that associates with the Golgi apparatus and regulates the early secretory pathway of proteins. The encoded protein promotes hydrolysis of ADP-ribosylation factor 1 (ARF1)-bound GTP, which is required for the dissociation of coat proteins from Golgi-derived membranes and vesicles. Dissociation of the coat proteins is a prerequisite for the fusion of these vesicles with target compartments. The activity of this protein is sensitive to phospholipids. Multiple transcript variants encoding different isoforms have been found for this gene. This gene was originally known as ARFGAP1, but that is now the name of a related but different gene.
仅用于科研。不用于诊断过程。未经明确授权不得转售。
生物信息学
蛋白别名: ADP ribosylation factor GTPase activating protein 3; ADP-ribosylation factor GTPase activating protein 1; ADP-ribosylation factor GTPase-activating protein 3; ARF GAP 3; ARF1GAP; ARFGAP1; arfgap3 {ECO:0000250|UniProtKB:Q9NP61}; FLJ45618; HRIHFB2281; MGC39924; OTTHUMP00000028526; RP1-47A17.3; RP11-261N11.1; unnamed protein product
基因别名: 0610009H19Rik; 1810004P07Rik; 1810035F16Rik; 9130416J18Rik; ARFGAP1; ARFGAP3
UniProt ID: (Human) Q9NP61, (Mouse) Q544V6, (Rat) Q4KLN7
Entrez Gene ID: (Human) 26286, (Mouse) 66251, (Rat) 503165